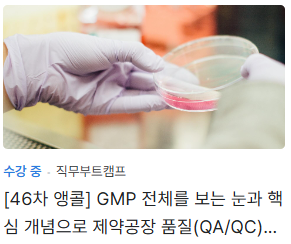

7시간 18분 17초 후 가격이 인상돼요!

5주간 현직자와 제대로 품질 직무 경험을 만들 수 있습니다.
현직자의 진짜 실무를 멘토의 도움을 받아 수행합니다.
업무에 대한 1:1 피드백과 코칭이 매주 제공됩니다.
5주간 3회의 세션을 가지게 되며, 학업/현업과 병행 가능합니다.
안녕하십니까? 23년 이상 의약품 GMP 업무를 하고 있는 멘토입니다.
환자 보호를 위하여 GMP는 의약품 공장에 근무하게 되면 누구나 반드시 준수하여야 하는 품질보증시스템입니다. (GMP 위반은 불법입니다!)
의약공장에 와서 처음 GMP를 접하였을 때 생소한 용어, 난해하게 느껴지는 개념 및 체계로 그리고 잘 알고 가르쳐 주는 사람도 없었기에 그 당시 저는 업무하기가 쉽지 않았습니다. 그렇다고 GMP를 피할 수도 없어서 그 때 많이 난감하였습니다. 지금와서 생각해 보니 그 당시 좋은 GMP 스승이 있었으면 용이하고 효율적인 지름길을 통하여 더욱 잘 할 수 있었으면 하는 아쉬움이 있습니다.
의약품 제조 공장에 취직을 원하는 멘티들이 입사 전후에 면접, 인턴, 실무를 통하여 반드시 직면하게 되는 GMP를 23년 의약품 GMP 경험을 통하여 알게 된 GMP 전반적인 개념, 핵심 요약 및 노하우를 전수하여 이해하고 설명할 수 있는 역량을 멘티들께 드리고 싶습니다.
- GMP를 통한 의약품 품질 개념 (Safety, Purity, Efficacy, Stability),
- GMP에 의한 상업화 단계 (R&D, Technology transfer, Design/Engineering, Qualification/Validation, Manufacturing, CTD/DMF),
- GMP 시스템 (Quality, Production, Facilities and equipment, Laboratory controls, Materials, Packaging and labeling),
- GMP 요소 4M+1E (Man, Machine, Material, Method, Environment),
- GMP에서 요구하는 품질 시스템 (Compliance, Documentation, Training, Materials control, Batch review & release, Change control, Investigation & CAPA, Annual review, Inspection/Audit),
- GMP 경영을 위한 Quality risk management
위와 같은 GMP 전체를 보는 눈과 핵심 개념을 탑재한 두뇌를 멘티들께서 이번 기회를 통하여 제공하고 싶습니다.
GMP가 멘티들의 경력에서 걸림돌에서 디딤돌로 변하게 하는 GMP 캠프를 같이 행복하게 만들어 봅시다.
직무부트캠프를 추천합니다.
직무경험이 없어요.
직무경험이 없어요.
직무경험이 없어요.
실제 취업에 도움이 됩니다.
직무부트캠프에서 했던 경험과 배웠던 직무 전문 단어를 면접에서 활용하였더니 면접관들이 흥미를 보였고, 결국 최종 합격했어요.
남00님
수료증을 토대로 이력서에 직무 관련 경험으로 작성했고 임원 면접시 경험에 대한 질문에 직무 관련한 관심이 많다는 것으로 어필 했고, 좋은 평가를 받을 수 있었어요.
강00님

현 의약품 GMP 경력 23년 이상
- 의약품제조 QA , QC , 개발
- 품질관리기술사
- EU/일본/우리나라 완제의약품 및 원료의약품 GMP 인증 획득 (GMP 인증 책임자)

G씨! 시약 제조처에서 보관 조건만 알려 주고 있고 유효기간이 없는 QC 시약들이 많이 있는데 품질 위험 관리 차원에서 각각의 시약에 대하여 유효기간을 설정하여 보고서를 제출하면 좋겠습니다.
M씨! 함량 기준이 90에서 110%인데 이번 lot가 92%가 나와서 부적합은 아니지만 낮은 값이기 때문에 공정에 이상이 있는지 확인해 봐야 합니다. 공정 이상 원인이 될 수 있는 것들이 무엇이 있는지 조사하신 후 보고하여 주십시오. 그리고, 공정은 이상 없으나 시험 오류가 있을 수 있으니 그에 대한 원인들이 또 무엇이 있는지도 같이 조사 보고 부탁 드립니다.
P씨! 요새 GMP 실사를 허가 당국과 고객사로부터 받게 되면 Data integrity를 꼭 확인하게 되는데 Data integrity를 보증하기 위하여 QC의 여러 분석 장비에서 나오는 data를 관리하기 위한 방법을 수립하여 보고를 하십시오. 물론 장비 별로 적절하게 차별 된 방법이 필요하겠지요. 잘 아시는 것처럼 제한된 자원과 시간으로 GMP를 잘 적용하여야 되기 때문이죠.
멘토씨! 신입 사원들에게 우리나라 법규 '의약품 제조 및 품질관리에 관한 규정'으로 GMP 교육한 후 교육 평가를 위하여 시험을 보게 하여야 합니다. 관련 법규 중 특히 '원료의약품 제조'와 '완제의약품 제조' 내용으로 시험 문제를 출제하십시오. 특별히 중요하거나 혼동하기 쉬운 개념이 기술된 내용의 법조문을 선택한 후 그 내용 중 핵심 단어를 지우고 괄호로 대체하여 시험 문제로 출제하면 됩니다.
과제 소개
제약회사 품질 부서(QA/QC)에서 실제로 일어날 수 있는 과제를 선정하였습니다.
QC에서 사용하는 여러 종류의 시약이 있고 제조처에서 요구하는 보관 조건은 있지만 유효기간이 없는 경우에 품질을 보증하면서 품질 위험 평가에 따른 그룹 별로 유효 기간을 설정하여 GMP와 risk management 개념을 이해할 수 있도록 하였습니다.
공정 이상이 발생한 경우에 그에 대한 원인 분석을 할 수 있고 공정 이상 판단 전에 관련된 시험 결과에 대한 오류의 원인 분석의 관점을 갖도록 하였습니다.
가장 중요한 GMP issue 중에 하나인 data integrity를 보증하기 위하여 QC의 다양한 분석 장비 별로 적절한 data 관리 방법을 수립함에 따라 역시 GMP와 risk management 개념을 활용하도록 하였습니다.
과제를 통하여 얻어갈 수 있는 것
GMP의 핵심 개념과 용어를 이해할 수 있습니다.
GMP와 Risk management 개념에 따라서 QA와 QC의 개념과 실제 업무 진행하는 관점과 방법을 알 수 있습니다.
알려드릴게요!
품질(QA/QC)직무에 대한 구직자들의 오해
문서 검토 위주의 QA 업무와 검사와 시험 위주의 QC 업무가 의약품 품질 직무라고 생각하기 쉽습니다.
그러나 이것만으로는 부족합니다. 왜냐하면 일반 제조업과 달리 인간의 생명과 건강에 직접 영향을 끼치는 의약품을 제조하는 업무이기 때문에 의약품 품질 보증 시스템인 GMP와 품질 관점에서 선택과 집중 시스템인 Risk management에 대한 철학과 이해를 바탕으로 한 업무 전개가 필수적입니다.
그리고 GMP과 risk management 개념과 용어를 사전에 제대로 알아야 업무 적응이 수월합니다.
품질(QA/QC)직무가 실제로 하는 일
연구소와 다른 업체로부터 기술이전 및 위수탁 관리, Validation, 원자재/공정품/완제품/환경 시험 및 적합 판정, 문서와 교육 관리, 품질 이상에 대한 조사, 변경 관리, 연간 품질 평가, 감사 및 수검 업무를 통하여 품질 경영을 수행합니다.
과제 수행을 통해 키울 수 있는 역량
의약품 품질 경영을 위한 두 가지 핵심 개념인 GMP와 Risk management에 대한 이해와 관점을 갖게 됩니다.
현업자 수준의 직무 이해도를 얻게됩니다.
⋅ 직무담당자가 실제로 하는 일
⋅ 직무담당자로 일하는 장, 단점과 요구 역량
⋅ 주차 별 프로젝트 소개 및 선정 이유
Risk assessment(RA)에 의하여 QC 분석용 시약의 유효기간을 설정한 후 보고하십시오. (ICH guideline Q9 Quality Risk Management)
1. 유효기간에 영향을 미치는 시약의 종류, 특성, 보관 조건, 사용빈도 구분
2. 유효기간 영향 인자에 따른 RA에 의한 유효기간 결정
*과제 결과물 : A4 1 page 분량
공정에서 품질변동 원인과 QC에서 시험 오류 원인에 대하여 보고하십시오. [Out-of-trend(Out-of-alert/action), Failure, OOS investigation]
1. 5M(4M + measurement)관점에서 공정 이상 원인
2. 5M(4M + measurement)관점에서 시험 오류 원인
*과제 결과물 : A4 1 page 분량
Data integrity를 보증하기 위한 QC 시험 장비 별로 data 관리 방법을 보고하십시오. (ALCOA data integrity)
1. Data 관리, Access 관리 및 Audit trail의 의한 data integrity 보증 방법
2. Risk assessment에 의한 QC 시험 장비 등급 분류 및 그에 따른 data integrity 보증 방법
*과제 결과물 : A4 1 ~2 page 분량
식품의약품안전처고시 제2019-52호 의약품 제조 및 품질관리(GMP)에 관한 규정 중 다음에 해당되는 내용을 읽고 시험 문제 및 답안 제출
1. 원료의약품 제조
2. 완제의약품 제조
*품질관리(GMP) 규정 참고 사이트 : http://www.law.go.kr/admRulLsInfoP.do?admRulSeq=2100000180157
*과제 결과물 : A4 2~3 page 분량
업무 요청서로 전달됩니다.




교과 외 활동 항목에 직무부트캠프 수료 경험을 활용할 수 있습니다.

채용지원 마감일과 캠프 종료일 차이로 수료증 활용이 어려운 경우, 수료예정증명서를 발급해드립니다.
* 3주차 이상 경과된 경우에 한하여 고객센터를 통해 신청 가능
저와 5주간 함께 수행한 업무는 직무경험을 증명할 결과물이 됩니다.
*아래는 수강생들이 5주간 만든 실제 포트폴리오입니다.




이런 점이 좋습니다.
자소서와 면접 준비
업무 프로세스 이해
직무 적합도 판단

더 편안하고 자유롭게 소통할 수 있습니다.
더 뛰어난 학습 효과를 얻을 수 있습니다.
더 솔직한 이야기를 들을 수 있습니다.
직무를 깊게 경험해 보실래요?
완전히 해결됩니다!
- 정가
- 300,000원
- 얼리버드 38% 할인
- - 114,600원
- 후기 이벤트 원고료
- - 20,000원
- 최대 할인 적용가
- 33,080원 /1주
- 12개월 무이자 할부
- 3,180원 /1주
정부 지원금 사용 가능
신청자가 본인의 의사로 캠프참여를 포기한 경우
코멘토가 캠프진행을 할 수 없게 된 경우
캠프 시작전 취소(D-1일까지): 결제금액 전액 환불
1주차 시작일 ~ 2주차 시작일 D-1 : 결제금액의 2/3 환불
2주차 시작일 ~ 3주차 시작일 D-1: 결제금액의 1/2 환불
3주차 시작일 ~ 캠프 종료일: 환불 불가
1차 VOD강의 수강전 취소: 결제금액 전액 환불
1차 VOD 수강후 ~ 1차 과제 제출 전: 결제 금액의 2/3 환불
1차 과제 피드백 제공 후 ~ 2차 과제 제출 전: 결제금액의 1/2 환불
2차 과제 피드백 제공 후 ~ : 환불 불가
90일 만료 후 : 환불 불가
캠프 시작전 취소(D-2일까지): 쿠폰 재사용 가능
1주차 시작일 D-1 ~ 캠프 종료일: 쿠폰 재사용 불가
수강 취소 및 환불 의사를 표시하지 아니하고 무단결석 시는 교습시간으로 인지하며, 환불 요구시점 기준으로 반환합니다.
과제를 미제출하여 다음 번 캠프에 강제 참여하지 못하는 경우에는 해당차수 교습시간은 경과한 것으로 간주합니다.
캠프 참여율 80% 이상시 (세션 참여 3회 + 업무 제출 4회 중 총 6회 이상), 교육 수료증이 발급됩니다.
주차 별 업무를 기한 내 제출하지 않은 분들은 개별 업무 피드백을 받을 수 없습니다.
직무부트캠프는 현직자 리드멘토와 스터디메이트가 함께 만들어가는 프로그램입니다.
프로그램 분위기를 흐리거나 불성실하게 행동하는 분이 있을 시 참여 제재 조치를 받을 수 있습니다.
업무는 모두 개인업무로 진행되며, 업무 수행과 학업 및 취업준비의 병행이 가능합니다.(1주 평균 2~3시간 소요)
최소 인원 모집 미달 시 캠프 일정이 조정될 수 있습니다.